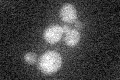
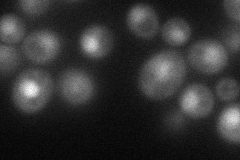
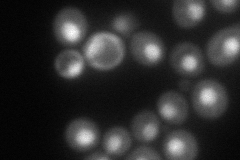
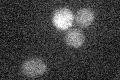

View description
Negative regulator of RNA polymerase III; component of several signaling pathways that repress polymerase III transcription in response to changes in cellular environment; targets the initiation factor TFIIIB
Localization:
Intensity:
Fold change:
Significance:
-
C’ GFP library in SD
below threshold17.9 -
N' NOP1pr-GFP in SD
nucleus54.8953 -
N' TEF2pr-mCherry in SD
nucleus108.692 -
N' NATIVEpr-GFP in SD

below threshold19.2175 -
N' TEF2pr-VC and Cyto-VN in SD

#N/A0 -
C’ GFP library in SD+DTT

cytosol15.730.87No -
C’ GFP library in SD+H2O2

cytosol17.680.98No -
C’ GFP library in Starvation Media
cytosol13.230.73No -
C’ GFP library on the background of Pup2-DaMP

below threshold -
C’ GFP library on the background of CCT mutant

below threshold18.43031.02931No
